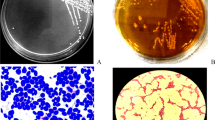

Abstract
Colorectal cancer (CRC) is one of the leading causes of cancer-related death worldwide. Accumulating evidence has suggested that probiotics affect cellular pathways and specific genes involved in slow growth. Probiotics reduce the impact or stop the growth of cancer cells and tumors in animal models and human cell lines. The aim of this study was to investigate the effect of Saccharomyces cerevisiae (S. cerevisiae) on cell growth, metastasis, and apoptosis of the HT-29 colon cancer cell line. The HT-29 cells and S. cerevisiae were co-cultured in order to study the effects of S. cerevisiae on cell apoptosis, growth, and metastasis using 4′,6-diamidino-2-phenylindole (DAPI) staining, 3-(4,5-dimethylthiazoyl-2-yl)-2,5-diphenyltetrazolium bromide (MTT) assay, and scratch wound-healing assay, respectively. Real-time PCR was applied to evaluate the expression levels of Akt/PTEN, MAPK, and NF-ĸB genes. The supernatant obtained from S. cerevisiae in HT-29 cell line increased the expression of PTEN and Caspas3 genes in the first 24 h while the Bclxl and RelA genes showed decreased expression. By using MTT method after 48 h of treatment HT-29 cells with supernatant of S. cerevisiae, about 75% of the cells showed stopped growing. Therefore, it could be concluded that S. cerevisiae inhibits the growth of the HT-29 cells by inducing apoptosis and reducing metastasis.
Similar content being viewed by others
Avoid common mistakes on your manuscript.
Background
Cancer occurs as a result of uncontrolled cell division caused by multifactor agents, such as environmental factors and genetic disorders (Benchekroun et al. 2010). Colorectal cancer can inflict the entire length of the rectum and colon. CRC is the third common cause of cancer-related death (dos Reis et al. 2017). It has been estimated that about 24.4 million new cases of CRC will be annually detected, by 2035 (Organization WH, Unit WHOMoSA 2014). Resistance to apoptosis and deregulation of cell proliferation are the major features of cancer cells. The agents that trigger apoptosis in cancer cells can be applied as anti-cancer drugs. However, resistance to chemotherapy has become a major problem in CRC treatment. It has been demonstrated that gastrointestinal cancers can be induced by the consumption of dietary products; therefore, some scientists have been attracted to investigate the impact of consuming dietary products on the health of the individuals. Probiotics are non-pathogenic organisms that are present in the human digestive system and exert beneficial effects on their host by affecting the microbial flora of the body. It has been found that certain probiotics exhibit anti-cancer activity (Daniluk 2012; Foo et al. 2011). Some studies conducted on human have previously proved the anti-cancer activity of probiotics (Commane et al. 2005). Numerous findings have indicated that probiotics may regulate cell division and apoptosis (Elmore 2007). Saccharomyces cerevisiae, as a species of yeast, has been widely used in the production of alcoholic beverages, waffles, and baking since ancient times (Feldmann 2011). Many of the major biological proteins, including cell cycle proteins, signaling proteins, and the processing enzymes, that have been initially found in human resemble those of the yeast (Walker et al. 2004). The HT-29 cell line is a human colon adenocarcinoma cell line, which provides a desirable experimental system for studying the effective factors in the differentiation of epithelial cells. These cells form non-polar layers, when cultured under standard conditions. These morphological characteristics of HT-29 cells make them a suitable model for studying various cell signaling pathways, as well as therapeutic agents or approaches. The polarized phenotypes of the cells are characterized by physiological biochemical markers as well as their specific structure (Cohen et al. 1999). PTEN (phosphatase and tensin homolog deleted on chromosome ten), a tumor suppressor gene, plays an important role in cell growth, proliferation, and migration (Saito et al. 2003). AKT, protein kinase B, is a hyperactivated kinase protein found in many tumors. AKT is a key player in both cell survival and resistance to tumor treatment. A recent study has reported that AKT cannot function unaided; however, it plays an important role in inhibiting cell death under severe conditions. Phosphorylation of the AKT gene inhibits the apoptosis pathway (Haier and Nicolson 2002). NF-ĸB is a protein set that controls DNA transcription, cell survival, cytokine production, and the regulation of immune response to the cancer. It is a heterodimer activator of transcription, which contains the DNA-binding subunit P50 and exuviates the trans-subunit p65/RelA (Vasudevan et al. 2004). The Bcl-2 family proteins, which include both anti- and pro-apoptotic proteins, regulate apoptosis; the Bcl-XL protein is a member of the bcl-2 family that prevents apoptosis.Therefore, extremely small changes in the physiological levels of these proteins may result in either inhibition or promotion of cell death. Abnormal activation of the Bcl-2 gene appears to be an early event in colorectal tumorigenesis that can inhibit apoptosis and may facilitate tumor progression (Sinicrope et al. 1995; Ola et al. 2011). Caspases (CASP) play an essential role in induced apoptosis (Kim et al. 2000; Jänicke et al. 1998; Yakovlev et al. 2001). Studies have demonstrated that activation of CASP3 induces apoptosis of HT-29 cells (Yang et al. 2006). The expression levels of the above mentioned genes were examined in the present study using realtime PCR. Our results indicated that the supernatant obtained from S. cerevisiae exerted beneficial effect in the HT-29 cell line by inducing apoptosis and reducing cell growth as well as metastasis.
Methods
Cell culture
The HT-29 cancer cells were obtained from the Pasteur Institute’s cellular storage (Iran) and stored at − 196 °C. Briefly, the HT-29 cells were cultured in 1640 RPMI, containing penicillin and streptomycin and 10% fetal bovine serum (FBS), and incubated at 37 °C in 5% CO2 (Wright et al. 1999; Nozari et al. 2016).
Yeast culture
The yeast was isolated from the local yogurt of Tabriz followed by determining its strain prior to being transferred to a plate containing the yeast culture media (peptone and distilled water, dextrose 40%, yeast extract, and agar). It was then incubated at 28 °C for 48 h (Cortes 2004). A yeast colony was then transferred to an YPD liquid culture (peptone and distilled water, dextrose 40%, and yeast extract) and was incubated in a shaking incubator for 48 h at 28 °C.
Co-culture of yeast and HT-29
The HT-29 cells were seeded in six-well plates (5 × 105 cells/cm2 per well) and incubated in 5% CO2 at 37 °C for 48 h. A single clone of the yeast was then cultivated in 1640 RPMI, containing 10% FBS, and incubated in a shaking incubator at 37 °C for 30 to 60 min. The culture medium containing the yeasts was then centrifuged at 1200 rpm (400g) for 5 min. The supernatant was separated, and its optic density (OD) was measured at 600 nm using a Spectrophotometer (Beckman, MO, USA; model DU-530). The above mentioned steps were repeated at various time intervals, and the ODs were measured at 600 nm. The HT-29 cells were cultured in six-well plates and washed twice with 2.5 ml PBS, prior to being treated with the prepared supernatant with specific ODs (0.3, 0.5, and 1), followed by 2 to 6-h incubation period in 5% CO2 at 37 °C. The supernatant was filtered through 0.22-μm filter before being added to the HT-29 cells (Westwater et al. 2005).
MTT assay
The HT-29 cells were first seeded in 96-well plates (5 × 103 cells/well) and incubated at 37 °C in 5% CO2 for 48 h. The cultured cells were treated with various concentrations of the S. cerevisiae supernatant (0.5, 0.25, 0.125, 0.0625, and 0.031 mg/ml). 5-Fluorouracil (5-FU) treated HT-29 cells were used as the positive control. The untreated cells were applied as the negative control. Half of the culture medium in each well (100 μl) was replaced with 100 μl of various concentrations of the S. cerevisiae supernatant. All the treatments were performed three times in triplicate. The cells were incubated at 37 °C and 5% CO2 for 12, 24, 48, and 72 h. The MTT assay was then performed for each treatment group) in this method, the dose-dependent time is used( (Bray and Carpenter 2013).
DAPI staining
A total of 5 × 105 cells/cm2 (HT-29 cells) were seeded in six-well plates and treated with various concentrations of S. cerevisiae for 12 h prior to being fixed with paraformaldehyde 4% for 10 min. The fixed cells were then washed three times with PBS and permeabilized with 0.1% Triton X-100 for 10 min. Finally, the cells were washed three times with PBS before being stained with DAPI for 5 min. An Olympus IX81 Inverted Fluorescence Microscope was applied to visualize the cells and acquire images at × 40 magnification (Sabnis n.d.).
Scratch assay
In vitro scratch assay was performed to evaluate the cell migration capability in a two-dimensional space. The cells were seeded in six-well plates (2 × 105 cells/cm2) and kept in culture to obtain confluent monolayers. The HT-29 cells were treated with supernatant of S. cerevisiae for 4, 24, and 72 h. The cells were then scratched using a scraper across the layer followed by two washing steps with PBS in order to remove the floating cells and cellular debris. The culture media were replaced with a serum-free medium (or 1% FBS) to inhibit cell proliferation. Images were then acquired periodically from the same field at 0-, 4-, 24-, and 72-h intervals (Liang et al. 2007).
DNA ladder assay
The treated cells were incubated at 37 °C for 24 h. The DNA ladder assay was performed based on a previously published procedure (Rahbar Saadat et al. 2015). Briefly, the treated cells were incubated in a lysis buffer 10 mM Tris (pH 7.4), 5 mM EDTA, and 0.2% Triton at 37 °C for 10 min. The protein lysate was then denaturized with 700 μl of chloroform/isoamyl alcohol (a ratio of 24:1), and the total DNA was separated by centrifugation at 13,000g. The total DNA was then precipitated using an equal volume of isopropranol and was electrophoresed on a 1.5% agarose gel containing 1 μl/100 ml SYBR® Safe DNA gel stain. The gel was finally examined and photographed using an ultraviolet gel documentation system.
Evaluation of the molecular mechanism of S. cerevisiae on HT-29
Expression analysis of pro- and anti-apoptosis genes in HT-29
Total RNA was extracted from the conditioned media-treated and untreated cells (Sepideh Zununi Vahed et al. 2016). The RNA yield and purity were determined by using a NanoDrop (NanoDrop, Wilmington, USA) instrument (Fleige 2006).
cDNA synthesis
In order to perform stem-loop quantitative reverse transcription and qRT-PCR analysis, 1 μg of each isolated total RNA sample was reversely transcribed using universal hexamer primers and diethyl pyrocarbonate (DEPC) water by incubating the mixture at 65 °C for 5 min followed by incubation on ice. The reaction solution was then mixed with MMLV, dNTP mix, RT buffer, and RNase inhibitor, and the volume of the solution was adjusted to 20 μl with DEPC water. Reverse transcription of the mRNAs was performed at 25 °C for 10 min followed by incubation at 42 °C for 60 min.
Gene regulation study
Real-time PCR was performed to measure the expression levels of the target mRNAs using SYBR Master Mix (Life Technologies Applied Biosystems, UK) and a Bio-Rad IQ5 Real-Time PCR instrument (Bio-Rad, Hercules, CA, USA). Q-RT PCR was performed at 95 °C for 30 s, followed by 45 cycles at 95 °C for 5 s, 60 °C (Table 1) for 30 s, and 72 °C for 25 s. Melt curves were generated at 95 °C to verify specificity of the amplification. To generate the standard curves, qPCR amplification of cDNA was performed using a serial dilution of the cDNA (10−1 to 10−4). GAPDH was used as an internal comparator in parallel with the control sample in order to normalize the expression levels of the intended mRNAs. Cycle number (CT) values were used to calculate the relative expression using the difference in the CT values of the target RNAs after normalization to the RNA input level. The relative quantification was represented by the standard 2−∆∆CT calculations. All the PCR reactions were performed in triplicate.
Statistical analysis
Numerical data were expressed as the mean ± SD. The Excel spreadsheet software (Microsoft, Redmond, WA) was applied for data analysis. Statistical analyses were performed using the Graphpad Prism (version 5; Graphpad Software, San Diego, CA) and one-way ANOVA test, followed by Tukey’s multiple comparison test. 푃 value < 0.05 was considered as statistically significant (Livak and Schmittgen 2001).
Results and discussion
MTT assay
Viability of the HT-29 cells was significantly reduced in response to treatment with the supernatant obtained from S. cerevisiae (Fig. 1). The cell death rate was more than 75% post-treatment with S. cerevisiae for 48 h (P < 0.05). All the in vitro results were expressed as the inhibition ratio of HT-29 cell proliferation as follows: an ELISA reader was applied to read the absorbance at 600 nm, and the inhibitory effect of S. cerevisiae on cell proliferation was then calculated to determine the IC50 values. The following formula was used to calculate the inhibitory rate:
The inhibitory effects of Saccharomyces cerevieses on proliferation rates of the HT-29 cell during various exposure period (12, 24, 48, and 72 h). In this method, the dose-dependent time is used. All the experiments were performed, at least, in triplicate. All the data are presented as mean (n = 3) ± 1 standard deviation. Different lowercase letters show intragroup difference (P < 0.05)
Evaluation of the nuclear morphology using DAPI staining
DAPI staining was applied to determine the nuclear morphology and integrity. The capability of the S. cerevisiae to induce apoptosis in the HT-29 cells cultured in the conditioned media was investigated using the microscopic analysis of the DAPI-stained cells (Fig. 2). As illustrated in Fig. 3, the control cells showed intact nuclei of uniform shape and size with smooth edges, whereas the nuclei of treated cells showed chromatin condensation and fragmentation.
Effects of Saccharomyces cerevisiae on induction of cell apoptosis in the HT-29 cells. The fluorescent microscopy of DAPI-stained HT-29 cells of a untreated control cells, b treated cells with Saccharomyces cerevisiae, and c treated cells with 5-FU. HT-29 human colorectal adenocarcinoma cell line, DAPI 4′,6-diamidino-2-phenylindole, 5-FU 5-fluorouracil
Cell migration was evaluated using scratch assay. The confluent cells were treated with the supernatant obtained from Saccharomyces cerevisiae (containing 1% FBS) for 0, 4, 24, and 72 h. a1, a2, a3, and a4 illustrate untreated cells, while the treated cells are presented in b1, b2, b3, and b4. FBS fetal bovine serum
Evaluation of cell migration using scratch assay
To study the effect of S. cerevisiae on the motility of HT-29 cells, scratch assay was performed by measuring the extent of cell migration into the scratched area. The cells were treated with the conditioned media for 24, 48, and 72 h. Cell migration was significantly inhibited in response to the S. cerevisiae treatment as shown in Fig. 3.
Detection of DNA fragmentation by DNA ladder assay
The DNA fragmentation is considered a hallmark of cell apoptosis. The results of the DNA ladder assay demonstrated that treatment of the HT-29 cells with the conditioned media resulted in the formation of the typical DNA ladder pattern (Fig. 4) indicating cell apoptosis.
S. cerevisiae treatment altered the expression of apoptosis genes in the HT-29 cells
To analyze the expression variation of certain pro-oncogenes that are reported to be over-expressed in cancer, their expression levels were measured in the S. cerevisiae-treated HT-29 cells 12 and 24 h post-treatment. S. cerevisiae significantly downregulated the expression levels of the intended pro-oncogenes in the HT-29 cells. Therefore, S. cerevisiae acted as a pro-apoptosis agent (Figs. 5, 6, 7, and 8).
The expression levels of PTEN gene in the Saccharomyces cerevisiae-treated HT-29 cells. The data are expressed as fold changes. S.C (12 h), HT-29 cells treated with Saccharomyces cerevisiae for 12 h; S.C (24 h), HT-29 cells treated with Saccharomyces cerevisiae for 24 h; S.C (5FU), HT-29 cells treated with 5FU; and Cnt, untreated HT-29 cells (used as the negative control). All the experiments were performed, at least, in triplicate. All the data are presented as mean (n = 3) ± 1 standard deviation (P < 0.05). PTEN phosphatase and tensin homolog deleted on chromosome ten, 5FU 5-fluorouracil, HT-29 human colorectal adenocarcinoma cell line
The expression levels of bcl-XL gene in the Saccharomyces cerevisiae-treated HT-29 cells. The data are expressed as fold changes. S.C (12 h), HT-29 cells treated with Saccharomyces cerevisiae for 12 h; S.C (24 h), HT-29 cells treated with Saccharomyces cerevisiae for 24 h; S.C (5FU), HT-29 cells treated with 5FU; and Cnt, untreated HT-29 cells (used as the negative control). All the experiments were performed, at least, in triplicate. All the data are presented as mean (n = 3) ± 1 standard deviation (P < 0.05). 5FU 5-fluorouracil, HT-29 human colorectal adenocarcinoma cell line
The expression levels of CASP3 gene in the Saccharomyces cerevisiae-treated HT-29 cells. The data are expressed as fold changes. S.C (12 h), HT-29 cells treated with Saccharomyces cerevisiae for 12 h; S.C (24 h), HT-29 cells treated with Saccharomyces cerevisiae for 24 h; S.C (5FU), HT-29 cells treated with 5FU; and Cnt, untreated HT-29 cells (used as the negative control). All the experiments were performed, at least, in triplicate. All the data are presented as mean (n = 3) ± 1 standard deviation (P < 0.05). 5FU 5-fluorouracil, HT-29 human colorectal adenocarcinoma cell line
The expression levels of RelA gene in the Saccharomyces cerevisiae-treated HT-29 cells. The data are expressed as fold changes. S.C (12 h), HT-29 cells treated with Saccharomyces cerevisiae for 12 h; S.C (24 h), HT-29 cells treated with Saccharomyces cerevisiae for 24 h; S.C (5FU), HT-29 cells treated with 5FU and Cnt, untreated HT-29 cells (used as the negative control). All the experiments were performed, at least, in triplicate. All the data are presented as mean (n = 3) ± 1 standard deviation (P < 0.05). 5FU 5-fluorouracil, HT-29 human colorectal adenocarcinoma cell line
Discussion
The results of the present study indicated that the expression levels of RelA and bcl-XL genes were significantly downregulated in the HT-29 cells treated with S. cerevisiae, while those of PTEN and CASP3 genes were markedly upregulated 24 h post-treatment. CRC is one of the deadliest cancers. Therefore, it has attracted global attention as it results in a high mortality rate (Liu et al. 2015; Ting Shuang et al. 2016; Gaikwad et al. 2015). Cognition of the molecular mechanisms underlying chemo-resistance is a critical step in improving the survival rate of the CRC patients (Sato and Itamochi 2015; Chen et al. 2009). Recent developments in the field of anti-cancer drug discovery are often related to drug design targeting a specific molecule or a signaling pathway. Various targets are used in anti-cancer drug development, including growth signaling cascades, cell division, DNA replication, angiogenesis, and apoptosis processes (Bernardes et al. 2010; Saber et al. 2017). Even though the gold standard of ovarian cancer management is still chemotherapy, employing adjunctive therapies are being rigorously investigated (Maria Muccioli 2014). The microbial-based therapy of cancer is one of the recently developing cancer treatment modalities (dos Reis et al. 2017; Bernardes et al. 2010). The protective and anti-cancer effects of probiotics have been reported in an in vitro, in vivo, epidemiologic, and clinical trials study conducted by Kim et al. The effects of the cellular components of the probiotics on 11 different cancer cell lines have been studied (Maria Muccioli 2014). It has been reported that probiotics significantly inhibited proliferation of the cancer cell lines (Kim et al. 2003). Ghoneum and Gollapudi have investigated the effect of heat-killed S. cerevisiae, isolated from yeast tablets, on non-metastatic and metastatic breast cancer cells. They have found that heat-killed S. cerevisiae induced apoptosis in their cells of interest (GHONEUM 2004). Moreover, Ravi Subbiah et al. have found that ergosterol (a 28-carbon sterol which is present in bread and yeast tablet) in vitro and in the presence of 17β-estradiol inhibited the proliferation of breast cancer cells (Ravi Subbiah and Abplanalp 2003). Hence, Chan et al. have studied the effect of S. cerevisiae on human liver cell line (HepG2) and found that it induced an anti-tumor effect as well as apoptosis in the intended cell line (Chan et al. 2004). Investigating the effects of heat-killed S. cerevisiae, isolated from yeast tablet, on the human tongue cancer cells (SCC-4 and SCC-9) and human colon cancer cells (Caco-2, DLD-1) indicated that S. cerevisiae induced apoptosis in these cells (Ghoneum et al. 2005). Demiret et al., in a study on treating breast cancer patients, have found that β-glucan extracted from S. cerevisiae induced peripheral blood monocyte proliferation and activation in the advanced breast cancer patients (Demir et al. 2007). The protective effects of β-glucan, extracted from S. cerevisiae, on damaged DNA and cellular toxicity have been investigated in the wild cell line, CHO-k1, and )xrs5(CHO using live cell survival tests, and it has been found that β-glucan maintained cell viability in both cells and prevented apoptosis (Oliveira et al. 2007a). Moreover, Ghoneum et al. have performed a similar experiment on mice and found that heat-killed S. cerevisiae reduced tumor volume in mice (Oliveira et al. 2007b; Ghoneum et al. 2008). Furthermore, Joon and his colleagues have reported that β-glucan, isolated from S. cerevisiae, enhanced the innate immune system, but little evidence was found for its anti-cancer activity (Yoon et al. 2008). Lee et al. have investigated the effects of S. cerevisiae on the survival and proliferation rates of the HT-29 cells using MTT and [3H] thymidine assays and found that it positively affected the cells (Lee et al. 2005a; Lee et al. 2005b).The results of a study conducted by Javmen et al. have indicated that β-glucan, derived from S. cerevisiae, induced cell death in the mouse hepatoma cells (Javmen et al. 2015). Baricault et al. have examined the effects of fermented milk on the growth and proliferation rates of the HT-29 cells and found that it induced an inhibitory effect on both the growth and proliferation (Baricault et al. 1995). Moreover, Tiptiri et al. have reported that Lactobacillus casei prevented growth and initiated apoptosis in the HT-29 cells (Tiptiri-Kourpeti et al. 2016). In a study performed by Zhung-Yuan Chen, it has been demonstrated that the Lactobacilli, isolated from fermented products, induced inhibitory effects on the growth of the human colonic carcinoma cell line, HT-29 (Chen et al. 2017). Furthermore, Lee et al. have found that S. boulardii effectively inhibited the survival and proliferation of the HT-29 (Lee et al. 2005b). The results of a study conducted by Jabber et al. have indicated that beta-glycan, extracted from S. cerevisiae, induced an inhibitory effect on the growth of the AMN3 cell line in dose- and time-dependent manners. They have reported that the greatest inhibitory effect of beta-glycan was detected at the concentration of 500 μg/ml 48 h post-treatment (Jabber et al. 2011). Chenet et al. have reported that S. boulardii prevented the induction of epidermal growth factor (EGF)-induced proliferation, and reduced cell colony formation and promoted apoptosis in the human colonic cancer cells, namely HT-29 and SW480 (Chen et al. 2009). Sougioultzis et al. have found that S. cerevisiae produced low molecular weight peptides (< 1 kDa) which blocked NF-kB activation by downregulating the NF-kB-mediated IL-8 gene expression in the intestinal epithelial cells and monocytes (Papatheodoridis et al. 2006). Hence, Kühle et al. have shown that S. cerevisiae decreased the expression levels of pro-inflammatory cytokine IL-1a, in the porcine intestinal epithelial cell lines (Van der Aa Kühle et al. 2005; Jacobson 2015). Orland et al. have studied the effects of heat-killed Bacillus ramenus (B. ramenus) GG and Bacillus paracoxus IMPC 2.1 on the DLD-1 colon cancer cell line and found that they inhibited cell growth or proliferation (Madempudi and Kalle 2017). Fortin et al. have examined the effects of β-glucan, extracted from the wall of S. cerevisiae, on the CRC cells and found that it inhibited the proliferation of the target cells (Fortin et al. 2018). Vahed et al. have treated the HT-29 cells with the conditioned medium, containing Lactobacillus mesenteroides, and studied apoptosis using DAPI staining, flow cytometry, DNA ladder assays, as well as real-time q-PCR and found that L. mesenteroides induced apoptosis via upregulation of the expression levels of CASP3 as well as downregulation of the expression levels of AKT, NF-κB, and Bcl-XL in the HT-29 cell line (Vahed et al. 2017). The present study investigated the effect of the S. cerevisiae supernatant on the HT-29 cells 12, 24, 48, and 72 h post-treatment. We found that the S. cerevisiae supernatant reduced both the proliferation and migration rates and increased apoptosis in the HT-29 cells.
Conclusion
The results of the present study indicated that the supernatant obtained from Saccharomyces cerevisiae significantly inhibited cell growth and induced apoptosis in the HT-29 cells. Saccharomyces cerevisiae is present in some of the world’s most popular foods, and studies have indicated that it can effectively inhibit the growth of cancer cells; therefore, we suggest performing further studies on other cancer cell lines.
References
Baricault L, Denariaz G, Houri J-J, Bouley C, Sapin C, Trugnan G (1995) Use of HT-29, a cultured human colon cancer cell line, to study the effect of fermented milks on colon cancer cell growth and differentiation. Carcinogenesis 16(2):245–252
Benchekroun MT, Saintigny P, Thomas SM, El-Naggar AK, Papadimitrakopoulou V, Ren H et al (2010) Epidermal growth factor receptor expression and gene copy number in the risk of oral cancer. Cancer Prev Res 3(7):800–809
Bernardes NSR, Chakrabarty AM, Fialho AM (2010) Microbial-based therapy of cancer current progress and future prospects. Bioengineered Bugs 1(3):178–190
Bray M, Carpenter A. Assay guidance manual. Eli Lilly & Company and the National Center for advancing translational Sciences 2013
Chan J, Cheung J, Luk S, Wu Y, Pang S, Fung K (2004) Anti-cancer and pro-apoptotic effects of an herbal medicine and Saccharomyces cerevisiae product (CKBM) on human hepatocellular carcinoma HepG2 cells in vitro and in vivo. Immunopharmacol Immunotoxicol 26(4):597–609
Chen X, Fruehauf J, Goldsmith JD, Xu H, Katchar KK, Koon HW et al (2009) Saccharomyces boulardii inhibits EGF receptor signaling and intestinal tumor growth in Apcmin mice. Gastroenterology 137(3):914–923
Chen Z-Y, Hsieh Y-M, Huang C-C, Tsai C-C (2017) Inhibitory effects of probiotic Lactobacillus on the growth of human colonic carcinoma cell line HT-29. Molecules. 22(1):107
Cohen E, Ophir I, Shaul YB (1999) Induced differentiation in HT29, a human colon adenocarcinoma cell line. J Cell Sci 112(16):2657–2666
Commane D, Hughes R, Shortt C, Rowland I (2005) The potential mechanisms involved in the anticarcinogenic action of probiotics. Mutat Res 591(1):276–289
Cortes J (2004) Natural history and staging of chronic myelogenous leukemia. Hematol Oncol Clin North Am 18(3):569–584
Daniluk U (2012) Probiotics, the new approach for cancer prevention and/or potentialization of anti-cancer treatment. J Clin Exp Oncol 1:2
Demir G, Klein H, Mandel-Molinas N, Tuzuner N (2007) Beta glucan induces proliferation and activation of monocytes in peripheral blood of patients with advanced breast cancer. Int Immunopharmacol 7(1):113–116
dos Reis SA, da Conceição LL, Siqueira NP, Rosa DD, da Silva LL, Maria do Carmo GP (2017) Review of the mechanisms of probiotic actions in the prevention of colorectal cancer. Nutr Res 37:1–19
Elmore S (2007) Apoptosis: a review of programmed cell death. Toxicol Pathol 35(4):495–516
Feldmann H (2011) Yeast: molecular and cell biology. John Wiley & Sons, Hoboken
Fleige S (2006) Pfaffl MW. RNA integrity and the effect on the real-time qRT-PCR performance. Mol Aspects Med 27(2):126–139
Foo N-P, Ou Yang H, Chiu H-H, Chan H-Y, Liao C-C, Yu C-K, Wang YJ (2011) Probiotics prevent the development of 1, 2-dimethylhydrazine (DMH)-induced colonic tumorigenesis through suppressed colonic mucosa cellular proliferation and increased stimulation of macrophages. J Agric Food Chem 59(24):13337–13345
Fortin O, Aguilar-Uscanga B, Vu KD, Salmieri S, Lacroix M (2018) Cancer chemopreventive, antiproliferative, and superoxide anion scavenging properties of Kluyveromyces marxianus and Saccharomyces cerevisiae var. boulardii cell wall components. Nutr Cancer 70(1):83–96
Gaikwad SM, Thakur B, Sakpal A, Singh RK, Ray P (2015) Differential activation of NF-kappaB signaling is associated with platinum and taxane resistance in MyD88 deficient epithelial ovarian cancer cells. Int J Biochem Cell Biol 61:90–102
GHONEUM M (2004) GOLLAPUDI S. Induction of apoptosis in breast cancer cells by Saccharomyces cerevisiae, the baker’s yeast, in vitro. Anticancer Res 24(3A):1455–1464
Ghoneum M, Hamilton J, Brown J, Gollapudi S (2005) Human squamous cell carcinoma of the tongue and colon undergoes apoptosis upon phagocytosis of Saccharomyces cerevisiae, the baker’s yeast, in vitro. Anticancer Res 25(2A):981–989
Ghoneum M, El-Din NKB, Noaman E, Tolentino L (2008) Saccharomyces cerevisiae, the baker’s yeast, suppresses the growth of Ehrlich carcinoma-bearing mice. Cancer Immunol Immunother 57(4):581–592
Haier J, Nicolson GL (2002) PTEN regulates tumor cell adhesion of colon carcinoma cells under dynamic conditions of fluid flow. Oncogene 21(9):1450–1460
Jabber AJ, Mahdi N, Yaseen N (2011) The effect of beta glucan extract of Saccharomyces cerevieses on cancer cell growth in vitro. Iraq J Cancer Med Genet 4:53–58
Jacobson J (2015) Yeasts as probiotics: established in animals, but what about man. Probiotics and Prebiotics: Current Research and Future Trends Caister Academic Press, Norfolk, UK, pp 115–134
Jänicke RU, Sprengart ML, Wati MR, Porter AG (1998) Caspase-3 is required for DNA fragmentation and morphological changes associated with apoptosis. J Biol Chem 273(16):9357–9360
Javmen A, Nemeikaite-Ceniene A, Grigiskis S, Jonauskiene I, Rudenkov M, Kacianauskas D et al (2015) S. cerevisiae β-glucan reduced viability of mouse hepatoma cells in vitro. Turk J Biol 39(4):562–566
Kim WH, Yeo M, Kim MS, Chun SB, Shin EC, Park JH, Park IS (2000) Role of caspase-3 in apoptosis of colon cancer cells induced by nonsteroidal anti-inflammatory drugs. Int J Color Dis 15(2):105–111
Kim JY, Woo HJ, Kim Y-S, Kim KH, Lee HJ (2003) Cell cycle dysregulation induced by cytoplasm of Lactococcus lactis ssp. lactis in SNUC2A, a colon cancer cell line. Nutr Cancer 46(2):197–201
Lee SK, Kim HJ, Chi SG, Kim YW, Chae MJ, Jung JH et al (2005a) Saccharomyces boulardii activates expression of peroxisome proliferator-activated receptor-γ through suppression of Nf-kb in Ht-29 cell. J Gastroenterol Hepatol 20:A123–A1A4
Lee SK, Kim HJ, Chi SG, Jang JY, Nam KD, Kim NH et al (2005b) Saccharomyces boulardii activates expression of peroxisome proliferator-activated receptor-gamma in HT-29 cells. The Korean Journal of Gastroenterology = Taehan Sohwagi Hakhoe Chi 45(5):328–334
Liang C-C, Park AY, Guan J-L (2007) In vitro scratch assay: a convenient and inexpensive method for analysis of cell migration in vitro. Nature Protocols 2(2):329–333
Liu G, Du P, Zhang Z (2015) Myeloid differentiation factor 88 promotes cisplatin chemoresistance in ovarian cancer. Cell Biochem Biophys 71(2):963–969
Livak KJ, Schmittgen TD (2001) Analysis of relative gene expression data using real-time quantitative PCR and the 2− ΔΔCT method. Methods 25(4):402–408
Madempudi RS, Kalle AM (2017) Antiproliferative effects of Bacillus coagulans Unique IS2 in colon cancer cells. Nutr Cancer 69(7):1062–1068
Maria Muccioli FB (2014) Toll- like receptors in ovarian cancer as targets for immunotherapies. Front Immunol 5:1–5
Nozari S, Mohammadzadeh M, Faridvand Y, Tockmechi A, Movassaghpour A, Abdolalizadeh JJAoIM (2016) The study of extracellular protein fractions of probiotic candidate bacteria on cancerous cell line Arch Iran Med 19(11):779–785
Ola MS, Nawaz M, Ahsan H (2011) Role of Bcl-2 family proteins and caspases in the regulation of apoptosis. Mol Cell Biochem 351(1–2):41–58
Oliveira RJ, Matuo R, Da Silva AF, Matiazi HJ, Mantovani MS, LRJTiv R (2007a) Protective effect of β-glucan extracted from Saccharomyces cerevisiae, against DNA damage and cytotoxicity in wild-type (k1) and repair-deficient (xrs5) CHO. Cells 21(1):41–52
Oliveira RJ, Matuo R, Da Silva AF, Matiazi HJ, Mantovani MS, Ribeiro LR (2007b) Protective effect of β-glucan extracted from Saccharomyces cerevisiae, against DNA damage and cytotoxicity in wild-type (k1) and repair-deficient (xrs5) CHO cells. Toxicol Vitro 21(1):41–52
Organization WH, Unit WHOMoSA (2014) Global status report on alcohol and health, 2014. World Health Organization, Geneva
Papatheodoridis GV, Sougioultzis S, Archimandritis AJ (2006) Effects of Helicobacter pylori and nonsteroidal anti-inflammatory drugs on peptic ulcer disease: a systematic review. Clin Gastroenterol Hepatol 4(2):130–142
Rahbar Saadat YSN, Zununi Vahed S, Barzegari A, Barar J (2015) An update to DNA ladder assay for apoptosis detection. BioImpacts. 5(1):25–28
Ravi Subbiah M, Abplanalp W (2003) Ergosterol (major sterol of baker’s and brewer’s yeast extracts) inhibits the growth of human breast cancer cells in vitro and the potential role of its oxidation products. Int J Vitam Nutr Res 73(1):19–23
Saber A, Alipour B, Faghfoori Z, Yari Khosroushahi A (2017) Cellular and molecular effects of yeast probiotics on cancer. Crit Rev Microbiol 43(1):96–115
Sabnis R. n.d. 4, 6-Diamidino-2-phenylindole dihydrochloride (DAPI). Handbook of Fluorescent Dyes and Probes.145–7.
Saito Y, Swanson X, Mhashilkar A, Oida Y, Schrock R, Branch C et al (2003) Adenovirus-mediated transfer of the PTEN gene inhibits human colorectal cancer growth in vitro and in vivo. Gene Ther 10(23):1961–1969
Sato S, Itamochi H (2015) Ovarian cancer and drug resistance. Current Obstetrics and Gynecology Reports 4(1):18–25
Sepideh Zununi Vahed AB, Saadat YR, Mohammadi S, Samadi N (2016) A microRNA isolation method from clinical samples. BioImpacts 6(1):25–31
Sinicrope FA, Cleary KR, Stephens LC, Lee JJ, Levin B (1995) Bcl-2 and p53 oncoprotein expression during colorectal tumorigenesis. Cancer Res 55(2):237–241
Ting Shuang MW, Zhou Y, Shi C (2016) Over-expression of nuclear NF-κB1 and c-Rel correlates with chemoresistance and prognosis of serous epithelial ovarian cancer. Exp Mol Pathol 100:139–144
Tiptiri-Kourpeti A, Spyridopoulou K, Santarmaki V, Aindelis G, Tompoulidou E, Lamprianidou EE et al (2016) Lactobacillus casei exerts anti-proliferative effects accompanied by apoptotic cell death and up-regulation of TRAIL in colon carcinoma cells. PloS one. 11(2):e0147960
Vahed SZ, Barzegari A, Saadat YR, Goreyshi A, Omidi Y (2017) Leuconostoc mesenteroides-derived anticancer pharmaceuticals hinder inflammation and cell survival in colon cancer cells by modulating NF-κB/AKT/PTEN/MAPK pathways. Biomed Pharmacother 94:1094–1100
Van der Aa Kühle A, Skovgaard K, Jespersen L (2005) In vitro screening of probiotic properties of Saccharomyces cerevisiae var. boulardii and food-borne Saccharomyces cerevisiae strains. International Journal of Food Microbiology 101(1):29–39
Vasudevan KM, Gurumurthy S, Rangnekar VM (2004) Suppression of PTEN expression by NF-κB prevents apoptosis. Mol Cell Biol 24(3):1007–1021
Walker L, Aldhous M, Drummond H, Smith B, Nimmo E, Arnott I et al (2004) Anti-Saccharomyces cerevisiae antibodies (ASCA) in Crohn’s disease are associated with disease severity but not NOD2/CARD15 mutations. Clin Exp Immunol 135(3):490–496
Westwater C, Balish E, Schofield DA (2005) Candida albicans-conditioned medium protects yeast cells from oxidative stress: a possible link between quorum sensing and oxidative stress resistance. Eukaryot Cell 4(10):1654–1661
Wright K, Kolios G, Westwick J, Ward SG (1999) Cytokine-induced apoptosis in epithelial HT-29 cells is independent of nitric oxide formation. Evidence for an interleukin-13-driven phosphatidylinositol 3-kinase-dependent survival mechanism. J Biol Chem 274(24):17193–17201
Yakovlev AG, Ota K, Wang G, Movsesyan V, Bao W-L, Yoshihara K, Faden AI (2001) Differential expression of apoptotic protease-activating factor-1 and caspase-3 genes and susceptibility to apoptosis during brain development and after traumatic brain injury. J Neurosci 21(19):7439–7446
Yang S-A, Paek S-H, Kozukue N, Lee K-R, Kim J-A (2006) α-Chaconine, a potato glycoalkaloid, induces apoptosis of HT-29 human colon cancer cells through caspase-3 activation and inhibition of ERK 1/2 phosphorylation. Food Chem Toxicol 44(6):839–846
Yoon TJ, Kim TJ, Lee H, Shin KS, Yun YP, Moon WK et al (2008) Anti-tumor metastatic activity of β-glucan purified from mutated Saccharomyces cerevisiae. Int Immunopharmacol 8(1):36–42
Acknowledgements
This work was supported by Tabriz University of Medical Sciences and Islamic Azad University, Marvdasht.
Author information
Authors and Affiliations
Corresponding author
Ethics declarations
Conflicts of interest
The authors declare that they have no conflict of interest.
Ethical approval
This article does not contain any studies with human participants or animals performed by any of the authors.
Informed consent
This article does not need any informed consent.
Rights and permissions
About this article
Cite this article
Sambrani, R., Abdolalizadeh, J., Kohan, L. et al. Saccharomyces cerevisiae inhibits growth and metastasis and stimulates apoptosis in HT-29 colorectal cancer cell line. Comp Clin Pathol 28, 985–995 (2019). https://doi.org/10.1007/s00580-018-2855-6
Received:
Accepted:
Published:
Issue Date:
DOI: https://doi.org/10.1007/s00580-018-2855-6